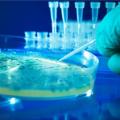
Ανακαλύφθηκε η πρώτη "κλειδαριά ασφαλείας" για γενετικά τροποποιημένους οργανισμούς

Μία ακόμη νέα αλλαγή ετοιμάζεται στο
Facebook και συγκεκριμένα στην αρχική
σελίδα του χρήστη.
Θα περιοριστούν λοιπόν...
Υπάρχει ένα βότανο, το οποίο δεν το υπολογίζουμε, όμως είναι θαυματουργό.
Ο τίτλος ίσως προκαλέσει εντύπωση σε πολλούς! Κι αυτό διότι το αυγό είναι μια παρεξηγημένη τροφή.
Από εδώ και πέρα οι χρήστες του Whats App θα μπορούν να έχουν την εφαρμογή και στον υπολογιστή τους, όπως ανακοινώθηκε από...
Η τέχνη του τατουάζ αλλάζει και χρόνια με τα χρόνια γίνεται όλο και πιο δημοφιλής παγκοσμίως, γι αυτό το λόγο...
Ένα κοινωνικό δίκτυο διαφορετικά απ΄ όλα τα άλλα έρχεται στο χώρο του ίντερνετ. Ονομάζεται Ideapod, όπου αναρτείς τις...
Το 33% των Ευρωπαίων χρηστών που μοιράζεται με άλλους συσκευές με σύνδεση στο διαδίκτυο, δεν λαμβάνει προληπτικά μέτρα...
Η αμερικανική εταιρεία τεχνολογίας, ηλεκτρονικών ειδών και λογισμικού Microsoft έκανε γνωστό ότι η αναβάθμιση των Windows 10...
Επιστήμονες στις ΗΠΑ κατάφεραν να ενσωματώσουν σε γενετικά τροποποιημένους μικροοργανισμούς μια γενετική...
Η λήψη ορμονικών αντισυλληπτικών (χαπιών, επιθεμάτων κ.α.) για τουλάχιστον πέντε συνεχόμενα χρόνια σχετίζεται με...
Από όλες τις οθόνες που διεκδικούν την προσοχή των παιδιών (τηλεόραση, υπολογιστής, κινητό κ.α.), τα παιδιά συνεχίζουν...